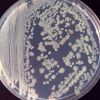

-
 +11 +1
+11 +1I had my poo tested to see if the science on gut bacteria stacks up
There are more than 1,000 species of bacteria fighting deep inside your body. But what does the makeup of that bacteria tell us about our health? Your digestive system is about seven metres long — dank folded passageways filled with rotting food and faeces and slick with bile.
-
 +26 +1
+26 +1A multicellular way of life for a multipartite virus
A founding paradigm in virology is that the spatial unit of the viral replication cycle is an individual cell. Multipartite viruses have a segmented genome where each segment is encapsidated separately. In this situation the viral genome is not recapitulated in a single virus particle but in the viral population. How multipartite viruses manage to efficiently infect individual cells with all segments, thus with the whole genome information, is a long-standing but perhaps deceptive mystery.
-
 +32 +1
+32 +1Stop sterilizing your dust
Most people have heard about antibiotic-resistant germs. But how about antibiotic-resistant dust? A new Northwestern University study has found that an antimicrobial chemical called triclosan is abundant in dust — and linked to changes in its genetic makeup. The result is dust with organisms that could cause an antibiotic-resistant infection.
-
 +24 +1
+24 +1A 5,000-year-old mass grave harbors the oldest plague bacteria ever found
A long-dead Scandinavian woman has yielded bacterial DNA showing that she contracted the earliest known case of the plague in humans. DNA extracted from the woman’s teeth comes from a newly identified ancient strain of Yersinia pestis, the bacterium that causes plague, the oldest ever found. The woman’s bones, which date from 5,040 to 4,867 years ago, were found nearly 20 years ago in a mass grave at an ancient farming site in Sweden.
-
 +21 +1
+21 +1Worms in space to understand muscle loss
Keeping fit and maintaining muscle strength is hard enough on Earth, but for astronauts in space it is even more important. As they float around the International Space Station working on experiments, their muscles and bones get less of a work-out than if they were walking and lifting objects on Earth.
-
+13 +1
+13 +1Antibiotic-resistant bacteria found on space station toilet
Wherever humans go, our bacterial companions will follow. That’s as true in space as it is on Earth, and while we’ve known that microbial astronauts are present on the International Space Station, one group of researchers has just found a new reason to worry about them.
-
 +3 +1
+3 +1How the Western Diet Has Derailed Our Evolution
For the microbiologist Justin Sonnenburg, that career-defining moment—the discovery that changed the trajectory of his research, inspiring him to study how diet and native microbes shape our risk for disease—came from a village in the African hinterlands.
-
 +24 +1
+24 +1Your poo is (mostly) alive. Here's what's in it
Around 75% of our faeces is made up of water. The other 25% is the good stuff, including bacteria, viruses and undigested food.
-
 +10 +1
+10 +1Chemists find a recipe that may have jump-started life on Earth
In the molecular dance that gave birth to life on Earth, RNA appears to be a central player. But the origins of the molecule, which can store genetic information as DNA does and speed chemical reactions as proteins do, remain a mystery. Now, a team of researchers has shown for the first time that a set of simple starting materials, which were likely present on early Earth, can produce all four of RNA’s chemical building blocks.
-
 +23 +1
+23 +1New test rapidly identifies antibiotic-resistant ‘superbugs’
When you get sick, you want the right treatment fast. But certain infectious microbes are experts at evading the very anti-bacterial drugs designed to fight them. A simple and inexpensive new test developed by UC Berkeley researchers can diagnose patients with antibiotic-resistant strains of bacteria in a matter of minutes.
-
 +6 +1
+6 +1Probiotics 'not as beneficial for gut health as previously thought'
Probiotics, hailed by some as a cure for all kinds of digestive ailments and recommended by many GPs alongside antibiotics, may not be as universally beneficial for gut health as previously thought. The gut microbiome is the sum total of all the micro-organisms living in a person’s gut, and has been shown to play a huge role in human health. New research has found probiotics – usually taken as supplements or in foods such as yoghurt, kimchi or kefir – can hinder a patient’s gut microbiome...
-
 +10 +1
+10 +1Jet hand dryers 'aerosolise' E. coli and other harmful bugs, scientists warn
Jet hand dryers spread dangerous bacteria around bathrooms and are significantly less hygienic than traditional paper towels, scientists have found. An international study in hospitals established that modern dryers create an aerosol effect, blasting E. Coli as well as traces of faeces and the bacteria responsible for septicaemia onto surfaces. While the devices can often be activated without being touched, which is supposed to improve hygiene, they are problematic because people fail to properly wash their hands, the experts said.
-
 +3 +1
+3 +1Something Digs Intricate Tunnels in Garnets. Is It Alive?
The deep red gems have long been found marred with internal markings. Researchers propose a new explanation involving fungal microorganisms who have found a nice place to live. By Veronique Greenwood.
-
 +32 +1
+32 +1A leading medical institution created a simulation that shows how a new disease could kill 900 million people — and it reveals how unprepared we are
The committee to advise the President first met approximately one month after the virus first appeared. There had been more than 400 cases and 50 deaths so far, mostly split between Frankfurt, Germany, and Caracas, Venezuela. Patients presented with fever, cough, and confusion. In a disturbing number of cases, encephalitis — swelling in the brain — caused patients to fall into a potentially fatal coma.
-
 +12 +1
+12 +1The right mix of gut microbes relieves autism symptoms in the long run
Giving children with autism a healthier mix of gut bacteria as a way to improve behavioral symptoms continued to work even two years after treatment ended. The finding may solidify the connection between tummy troubles and autism, and provide more evidence that the gut microbiome — the collection of bacteria and other microbes that live in the intestines — can influence behavior.
-
 +16 +1
+16 +1He was dying. Antibiotics weren't working. Then doctors tried a forgotten treatment
Phages are making a comeback. By Maryn McKenna.
-
 +11 +1
+11 +1Statins Damage Gut Microbiome and Contribute to Antibiotic Resistance
A recent study published in Nature has found that statins disturb the gut microbiome - they inhibit the growth of some potentially useful bacteria in the gut and allow other bacteria to flourish and become superbugs resistant to antibiotics.
-
 +3 +1
+3 +1First pilot for global expansion of the American Gut Project under The Microsetta Initiative
Researchers at the University of California San Diego School of Medicine and the LifeScience Institute in the Philippines have announced a pilot
-
 +19 +1
+19 +1Faecal transplants could help preserve vulnerable species
New gut bacteria can expand the diet of animals like koalas and rhinoceroses.
-
 +12 +1
+12 +1Global warming linked with rising antibiotic resistance
New research suggests rising temperatures are encouraging antibiotic resistance in cities across the United States. Until now, health researchers assumed antibiotic resistance was primarily the result of overprescription and overuse. But a new study suggests climate change is also to blame. "The effects of climate are increasingly being recognized in a variety of infectious diseases, but so far as we know this is the first time it has been implicated in the distribution of antibiotic resistance over geographies," Derek MacFadden, an infectious disease specialist and...
Submit a link
Start a discussion




















